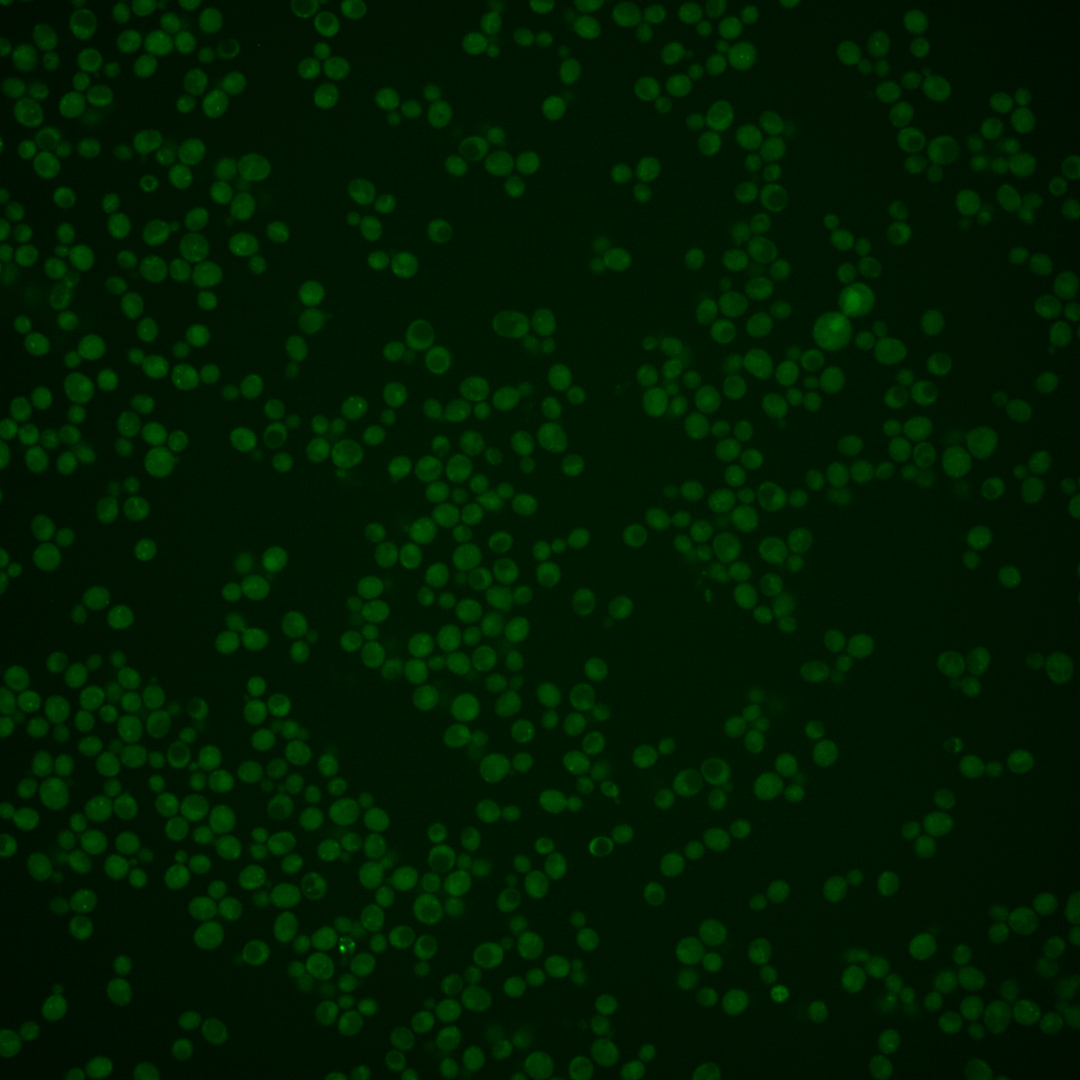
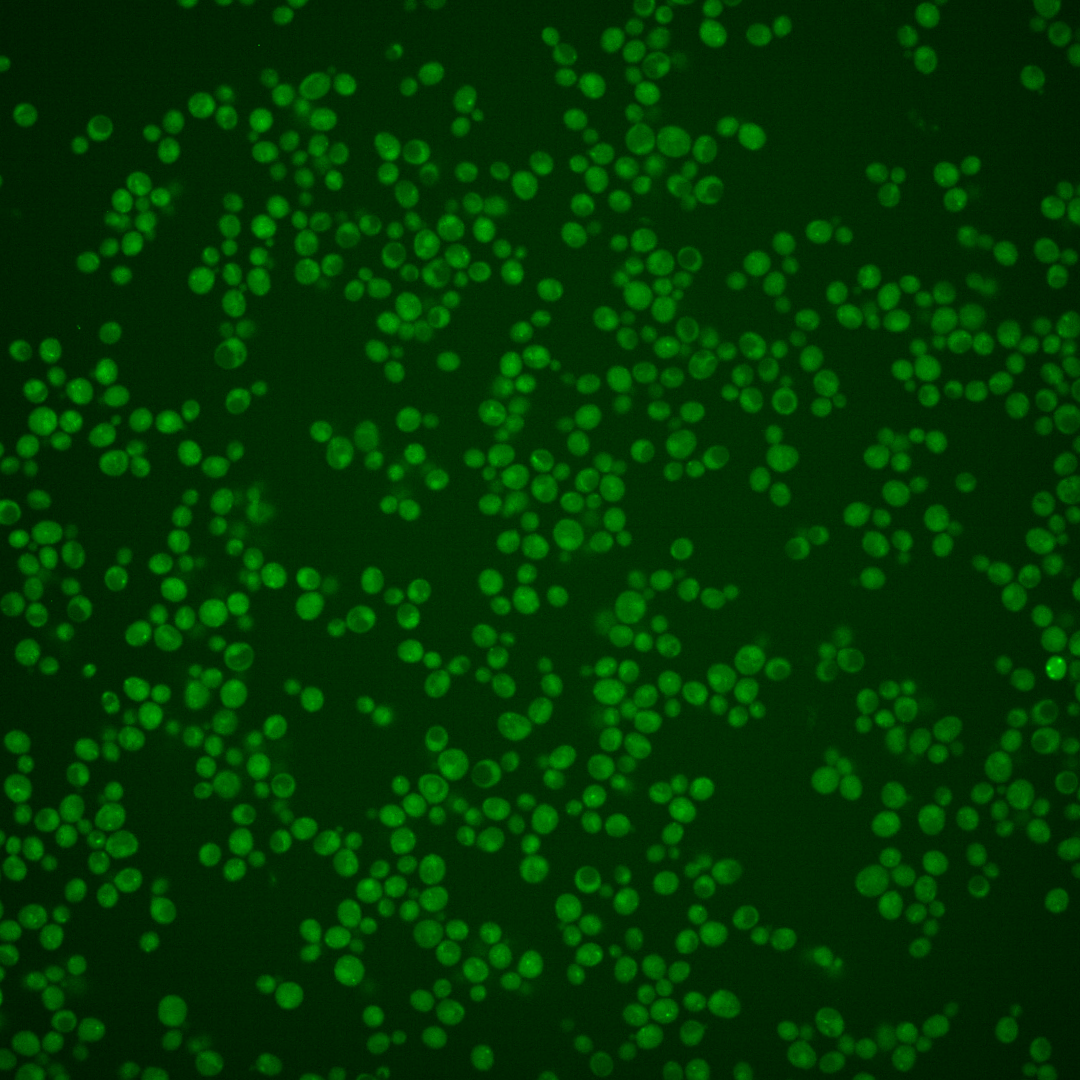
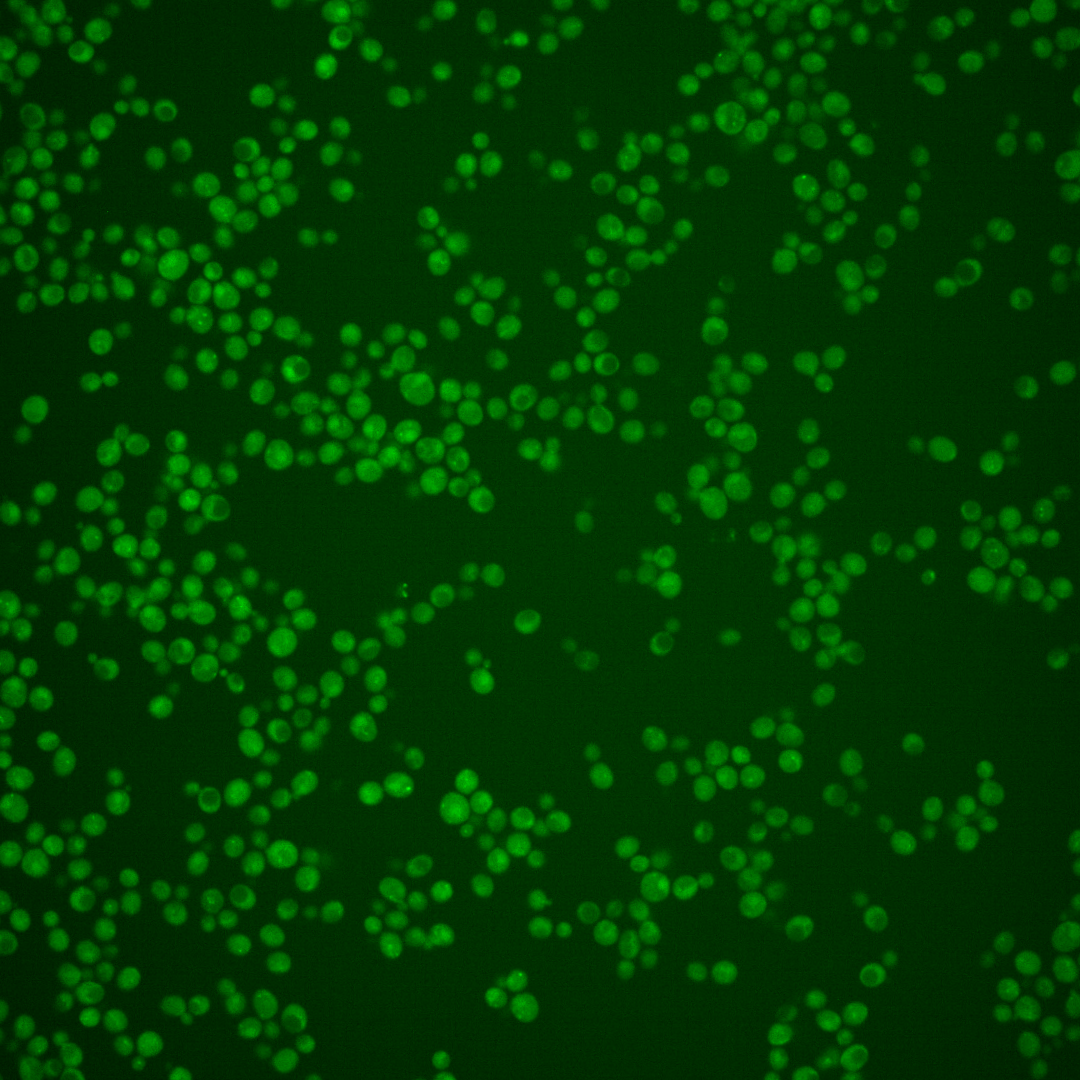
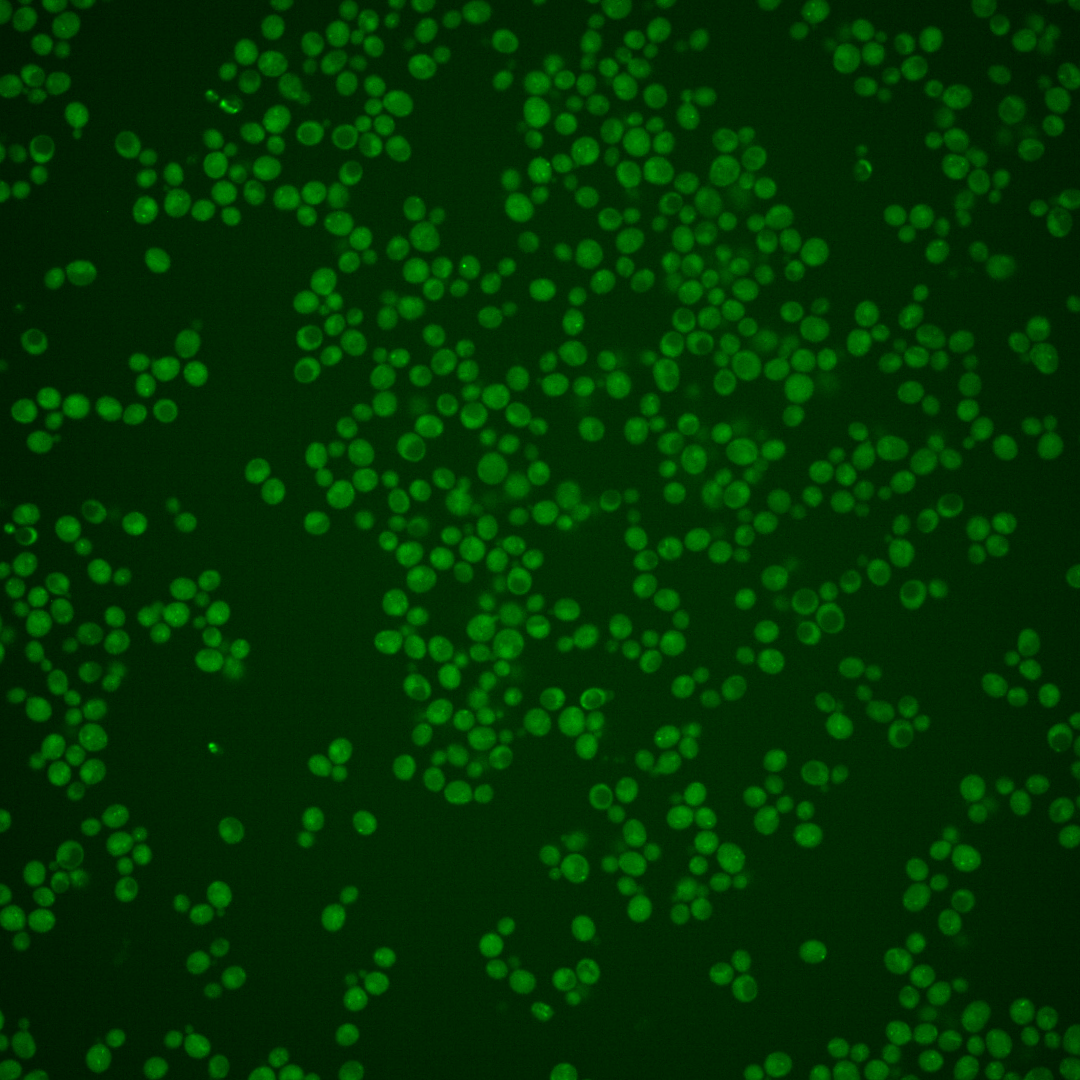
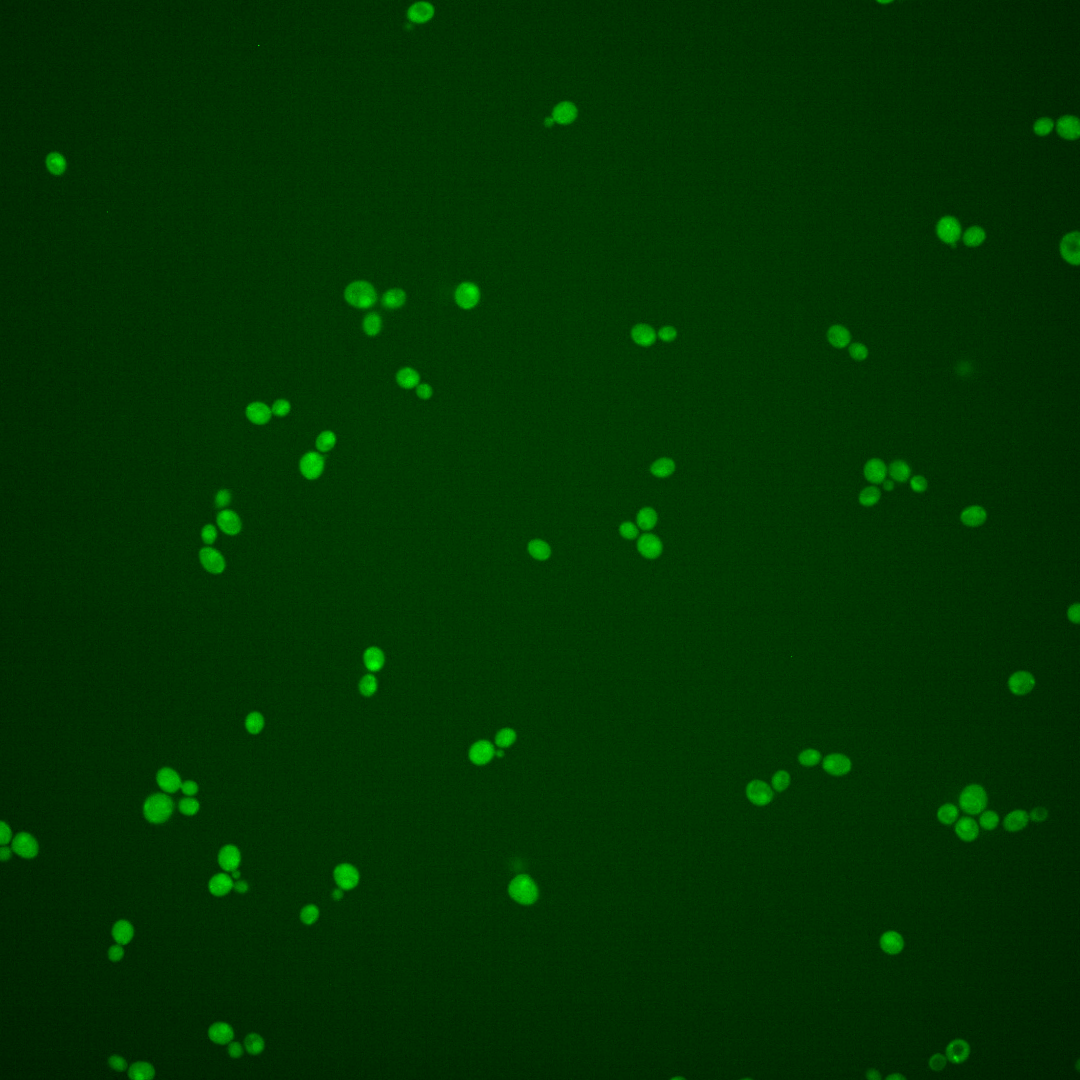

| Standard name | |
|---|---|
| Human Ortholog | |
| Description | Gamma-glutamyltranspeptidase; major glutathione-degrading enzyme; involved in detoxification of electrophilic xenobiotics; expression induced mainly by nitrogen starvation |
Micrographs




















































































Sub-cellular Localization
Yeast GFP Assignment
Protein Abundance
Localization Change
External localization resources
| ensLOC | DeepLoc | |||||||||||||||||||||||
|---|---|---|---|---|---|---|---|---|---|---|---|---|---|---|---|---|---|---|---|---|---|---|---|---|
| Localization | WT1 | WT2 | WT3 | RAP60 | RAP140 | RAP220 | RAP300 | RAP380 | RAP460 | RAP540 | RAP620 | RAP700 | HU80 | HU120 | HU160 | rpd3Δ_1 | rpd3Δ_2 | rpd3Δ_3 | WT1 | WT2 | WT3 | AF100 | AF140 | AF180 |
| Cortical Patches | 0 | 0 | – | 0 | 0 | 0 | 0 | 0 | 0 | 0 | 0 | 0 | 0 | 0 | 0 | 0 | 0 | 0 | 0 | 0 | 0 | 0 | 0 | 0 |
| Bud | 0 | 0 | – | 1 | 0 | 0 | 0 | 0 | 0 | 0 | 1 | 1 | 0 | 1 | 0 | 0 | 0 | 0 | 1 | 1 | 0 | 0 | 3 | 3 |
| Bud Neck | 0 | 0 | – | 0 | 0 | 0 | 0 | 0 | 0 | 0 | 0 | 0 | 0 | 0 | 0 | 0 | 1 | 0 | 0 | 0 | 0 | 1 | 0 | 1 |
| Bud Site | 0 | 0 | – | 0 | 0 | 0 | 0 | 0 | 0 | 0 | 0 | 0 | 0 | 0 | 0 | 0 | 0 | 0 | – | – | – | – | – | – |
| Cell Periphery | 0 | 0 | – | 1 | 1 | 0 | 0 | 0 | 0 | 0 | 0 | 0 | 0 | 0 | 0 | 2 | 0 | 1 | 0 | 0 | 0 | 0 | 0 | 0 |
| Cytoplasm | 110 | 85 | – | 61 | 76 | 62 | 95 | 135 | 49 | 102 | 92 | 171 | 89 | 221 | 346 | 213 | 224 | 156 | 14 | 10 | 2 | 9 | 34 | 31 |
| Endoplasmic Reticulum | 0 | 0 | – | 1 | 4 | 1 | 7 | 2 | 3 | 2 | 3 | 0 | 2 | 0 | 1 | 7 | 6 | 14 | 7 | 0 | 0 | 0 | 0 | 0 |
| Endosome | 13 | 7 | – | 0 | 3 | 2 | 0 | 3 | 0 | 0 | 0 | 0 | 1 | 0 | 0 | 8 | 6 | 5 | 11 | 9 | 0 | 1 | 5 | 6 |
| Golgi | 0 | 1 | – | 0 | 0 | 0 | 1 | 0 | 0 | 0 | 0 | 0 | 0 | 0 | 0 | 2 | 5 | 0 | 1 | 0 | 0 | 0 | 0 | 3 |
| Mitochondria | 25 | 1 | – | 0 | 1 | 2 | 11 | 6 | 5 | 10 | 13 | 9 | 0 | 0 | 1 | 8 | 9 | 4 | 2 | 3 | 0 | 0 | 4 | 5 |
| Nucleus | 20 | 9 | – | 4 | 26 | 45 | 71 | 88 | 37 | 36 | 29 | 28 | 11 | 4 | 1 | 16 | 22 | 14 | 1 | 1 | 0 | 1 | 2 | 3 |
| Nuclear Periphery | 4 | 1 | – | 1 | 0 | 0 | 0 | 0 | 0 | 0 | 0 | 2 | 0 | 0 | 0 | 0 | 0 | 0 | 0 | 0 | 0 | 0 | 0 | 0 |
| Nucleolus | 8 | 0 | – | 0 | 0 | 0 | 0 | 0 | 0 | 0 | 0 | 1 | 0 | 0 | 0 | 0 | 0 | 0 | 0 | 0 | 0 | 0 | 0 | 1 |
| Peroxisomes | 0 | 0 | – | 0 | 0 | 0 | 0 | 0 | 0 | 0 | 0 | 0 | 0 | 0 | 0 | 0 | 0 | 0 | 0 | 0 | 0 | 0 | 0 | 0 |
| SpindlePole | 1 | 0 | – | 0 | 1 | 1 | 1 | 0 | 0 | 0 | 0 | 0 | 0 | 0 | 0 | 0 | 0 | 2 | 0 | 0 | 0 | 0 | 2 | 2 |
| Vac/Vac Membrane | 87 | 93 | – | 31 | 128 | 114 | 215 | 217 | 79 | 117 | 96 | 174 | 15 | 34 | 15 | 166 | 181 | 133 | 272 | 149 | 36 | 71 | 191 | 217 |
| Unique Cell Count | 220 | 164 | 92 | 190 | 170 | 326 | 347 | 132 | 207 | 178 | 300 | 104 | 247 | 354 | 335 | 367 | 273 | 318 | 179 | 42 | 87 | 249 | 280 | |
| Labelled Cell Count | 268 | 197 | 100 | 240 | 227 | 401 | 451 | 173 | 267 | 234 | 386 | 118 | 260 | 364 | 422 | 454 | 329 | 318 | 179 | 42 | 87 | 249 | 280 | |
Yeast GFP Assignment
Protein Abundance
| Screen | WT1 | WT2 | WT3 | RAP60 | RAP140 | RAP220 | RAP300 | RAP380 | RAP460 | RAP540 | RAP620 | RAP700 | HU80 | HU120 | HU160 | rpd3Δ_1 | rpd3Δ_2 | rpd3Δ_3 | AF100 | AF140 | AF180 |
|---|---|---|---|---|---|---|---|---|---|---|---|---|---|---|---|---|---|---|---|---|---|
| Mean Cell GFP Intensity (1e-4) | 4.4 | 5.3 | – | 6.1 | 7.9 | 7.2 | 7.1 | 7.3 | 5.8 | 6.1 | 5.6 | 6.0 | 5.6 | 5.6 | 5.2 | 6.5 | 6.4 | 7.6 | 4.7 | 5.6 | 5.9 |
| Std Deviation (1e-4) | 0.7 | 0.9 | – | 1.6 | 1.6 | 1.5 | 1.5 | 1.7 | 1.4 | 1.5 | 1.4 | 1.4 | 1.1 | 1.6 | 1.1 | 1.4 | 1.6 | 4.8 | 0.7 | 1.3 | 2.1 |
| Intensity Change (Log2) | – | – | – | – | – | – | – | – | – | – | – | – | – | – | – | – | – | – | – | – | – |
Localization Change
| Localization | RAP60 | RAP140 | RAP220 | RAP300 | RAP380 | RAP460 | RAP540 | RAP620 | RAP700 | HU80 | HU120 | HU160 | rpd3Δ_1 | rpd3Δ_2 | rpd3Δ_3 |
|---|---|---|---|---|---|---|---|---|---|---|---|---|---|---|---|
| Actin | – | – | – | – | – | – | – | – | – | – | – | – | – | – | – |
| Bud | – | – | – | – | – | – | – | – | – | – | – | – | – | – | – |
| Bud Neck | – | – | – | – | – | – | – | – | – | – | – | – | – | – | – |
| Bud Site | – | – | – | – | – | – | – | – | – | – | – | – | – | – | – |
| Cell Periphery | – | – | – | – | – | – | – | – | – | – | – | – | – | – | – |
| Cyto | – | – | – | – | – | – | – | – | – | – | – | – | – | – | – |
| Endoplasmic Reticulum | – | – | – | – | – | – | – | – | – | – | – | – | – | – | – |
| Endosome | – | – | – | – | – | – | – | – | – | – | – | – | – | – | – |
| Golgi | – | – | – | – | – | – | – | – | – | – | – | – | – | – | – |
| Mitochondria | – | – | – | – | – | – | – | – | – | – | – | – | – | – | – |
| Nuclear Periphery | – | – | – | – | – | – | – | – | – | – | – | – | – | – | – |
| Nuc | – | – | – | – | – | – | – | – | – | – | – | – | – | – | – |
| Nucleolus | – | – | – | – | – | – | – | – | – | – | – | – | – | – | – |
| Peroxisomes | – | – | – | – | – | – | – | – | – | – | – | – | – | – | – |
| SpindlePole | – | – | – | – | – | – | – | – | – | – | – | – | – | – | – |
| Vac | – | – | – | – | – | – | – | – | – | – | – | – | – | – | – |
| Cortical Patches | – | – | – | – | – | – | – | – | – | – | – | – | – | – | – |
| Cytoplasm | – | – | – | – | – | – | – | – | – | – | – | – | – | – | – |
| Nucleus | – | – | – | – | – | – | – | – | – | – | – | – | – | – | – |
| Vacuole | – | – | – | – | – | – | – | – | – | – | – | – | – | – | – |
External localization resources
Images






























Protein Concentration and Protein Localization Data
| R1 | R2 | R3 | ||||||||||||||||
|---|---|---|---|---|---|---|---|---|---|---|---|---|---|---|---|---|---|---|
| G1 Pre-START | G1 Post-START | S/G2 | Metaphase | Anaphase | Telophase | G1 Pre-START | G1 Post-START | S/G2 | Metaphase | Anaphase | Telophase | G1 Pre-START | G1 Post-START | S/G2 | Metaphase | Anaphase | Telophase | |
| Concentration | -0.562 | -0.6683 | -0.7141 | -1.0266 | -1.4666 | -0.5924 | -0.4617 | -0.043 | -0.1041 | -0.2942 | -0.3962 | -0.2256 | -1.1529 | -1.0593 | -1.2666 | -0.763 | -0.8083 | -0.9172 |
| Actin | 0.0483 | 0.0055 | 0.0223 | 0.001 | 0.0064 | 0.0232 | 0.031 | 0.0001 | 0.0022 | 0.0074 | 0.0002 | 0.0035 | 0.0271 | 0.0003 | 0.0148 | 0.0028 | 0.0844 | 0.0014 |
| Bud | 0.001 | 0.0004 | 0.0006 | 0.0002 | 0.0004 | 0.0005 | 0.0013 | 0.0009 | 0.0036 | 0.0023 | 0.002 | 0.0006 | 0.0007 | 0.0005 | 0.0011 | 0.0007 | 0.0018 | 0.0005 |
| Bud Neck | 0.0038 | 0.0003 | 0.0011 | 0.0004 | 0.0019 | 0.003 | 0.0073 | 0.0018 | 0.0036 | 0.0036 | 0.0016 | 0.0033 | 0.0018 | 0.0006 | 0.0043 | 0.0067 | 0.0056 | 0.0039 |
| Bud Periphery | 0.0021 | 0.001 | 0.0008 | 0.0004 | 0.0003 | 0.0007 | 0.0019 | 0.0017 | 0.0038 | 0.0065 | 0.0026 | 0.001 | 0.0016 | 0.0006 | 0.0022 | 0.0008 | 0.0036 | 0.0009 |
| Bud Site | 0.0043 | 0.0013 | 0.0046 | 0.0002 | 0.002 | 0.0008 | 0.0075 | 0.0046 | 0.0134 | 0.0235 | 0.0048 | 0.0009 | 0.0055 | 0.0024 | 0.0073 | 0.0166 | 0.0054 | 0.0008 |
| Cell Periphery | 0.0007 | 0.0005 | 0.0004 | 0.0002 | 0.0001 | 0.0003 | 0.0016 | 0.0008 | 0.0006 | 0.0018 | 0.0007 | 0.0008 | 0.0007 | 0.0005 | 0.0007 | 0.0004 | 0.0008 | 0.0005 |
| Cytoplasm | 0.1005 | 0.27 | 0.1881 | 0.2182 | 0.2432 | 0.3033 | 0.1279 | 0.2275 | 0.1714 | 0.162 | 0.1007 | 0.2338 | 0.154 | 0.1863 | 0.1641 | 0.2862 | 0.0707 | 0.2863 |
| Cytoplasmic Foci | 0.0674 | 0.0486 | 0.0721 | 0.1037 | 0.0288 | 0.0707 | 0.0614 | 0.0444 | 0.0561 | 0.0829 | 0.0879 | 0.0635 | 0.0729 | 0.0546 | 0.0608 | 0.0634 | 0.0952 | 0.0567 |
| Eisosomes | 0.0013 | 0.0003 | 0.0002 | 0.0003 | 0.0039 | 0.0001 | 0.0006 | 0.0001 | 0.0002 | 0.0003 | 0.0001 | 0.0001 | 0.0006 | 0.0001 | 0.0003 | 0.0002 | 0.0002 | 0 |
| Endoplasmic Reticulum | 0.0075 | 0.0048 | 0.0067 | 0.0043 | 0.005 | 0.0039 | 0.0076 | 0.0064 | 0.0038 | 0.0038 | 0.002 | 0.0053 | 0.005 | 0.0028 | 0.0034 | 0.0045 | 0.0036 | 0.0041 |
| Endosome | 0.1323 | 0.0786 | 0.1562 | 0.2428 | 0.2037 | 0.1624 | 0.0831 | 0.0811 | 0.0935 | 0.1247 | 0.2081 | 0.1473 | 0.1127 | 0.0913 | 0.1467 | 0.2095 | 0.192 | 0.1283 |
| Golgi | 0.0143 | 0.0011 | 0.0045 | 0.0016 | 0.0018 | 0.0094 | 0.012 | 0.0011 | 0.0052 | 0.0099 | 0.0079 | 0.0053 | 0.0153 | 0.0012 | 0.0054 | 0.0023 | 0.0186 | 0.0058 |
| Lipid Particles | 0.0332 | 0.0056 | 0.0123 | 0.0031 | 0.0035 | 0.0105 | 0.0472 | 0.0046 | 0.0111 | 0.0169 | 0.0324 | 0.0063 | 0.0344 | 0.0064 | 0.0103 | 0.0033 | 0.0268 | 0.0055 |
| Mitochondria | 0.0069 | 0.0017 | 0.0035 | 0.0017 | 0.0016 | 0.0115 | 0.0163 | 0.0033 | 0.0115 | 0.0436 | 0.0177 | 0.0028 | 0.0119 | 0.0015 | 0.0054 | 0.0024 | 0.0151 | 0.0044 |
| None | 0.4838 | 0.449 | 0.389 | 0.2972 | 0.2303 | 0.2058 | 0.4806 | 0.4871 | 0.5296 | 0.3134 | 0.3139 | 0.291 | 0.4169 | 0.4954 | 0.442 | 0.2275 | 0.3092 | 0.2733 |
| Nuclear Periphery | 0.0151 | 0.0025 | 0.0051 | 0.0042 | 0.0088 | 0.0032 | 0.0105 | 0.0037 | 0.002 | 0.0044 | 0.0018 | 0.0038 | 0.0054 | 0.0025 | 0.0033 | 0.0105 | 0.0032 | 0.0046 |
| Nucleolus | 0.0014 | 0.0011 | 0.0013 | 0.0009 | 0.0011 | 0.0013 | 0.003 | 0.0023 | 0.0024 | 0.0116 | 0.0048 | 0.0019 | 0.0025 | 0.0022 | 0.002 | 0.0011 | 0.0029 | 0.0033 |
| Nucleus | 0.0026 | 0.0033 | 0.0053 | 0.0029 | 0.0263 | 0.0209 | 0.0049 | 0.0088 | 0.0053 | 0.0164 | 0.0042 | 0.0131 | 0.006 | 0.0066 | 0.0039 | 0.0109 | 0.0054 | 0.0126 |
| Peroxisomes | 0.0231 | 0.0005 | 0.0152 | 0.0008 | 0.0023 | 0.0081 | 0.0183 | 0.0005 | 0.0063 | 0.0118 | 0.0049 | 0.0016 | 0.0179 | 0.0006 | 0.0033 | 0.001 | 0.0357 | 0.0013 |
| Punctate Nuclear | 0.0075 | 0.0019 | 0.0034 | 0.0013 | 0.0036 | 0.0174 | 0.0109 | 0.0012 | 0.0024 | 0.0061 | 0.0092 | 0.0027 | 0.0116 | 0.0016 | 0.0028 | 0.0018 | 0.005 | 0.0019 |
| Vacuole | 0.0364 | 0.1167 | 0.0976 | 0.1049 | 0.2012 | 0.1319 | 0.0605 | 0.1119 | 0.067 | 0.1308 | 0.1744 | 0.199 | 0.0883 | 0.1342 | 0.105 | 0.1245 | 0.1046 | 0.1903 |
| Vacuole Periphery | 0.0065 | 0.0054 | 0.0096 | 0.01 | 0.0239 | 0.011 | 0.0046 | 0.0058 | 0.0049 | 0.0163 | 0.018 | 0.0124 | 0.0072 | 0.0079 | 0.0108 | 0.0232 | 0.0103 | 0.0134 |
Sequencing Data
| R1 | R2 | |||||||||
|---|---|---|---|---|---|---|---|---|---|---|
| G1 Post-START | S/G2 | Metaphase | Anaphase | Telophase | G1 Post-START | S/G2 | Metaphase | Anaphase | Telophase | |
| Gene Expression | 13.6326 | 3.9793 | 15.5024 | 16.5219 | 12.2645 | 24.4694 | 14.4594 | 19.0091 | 20.1996 | 16.6846 |
| Translational Efficiency | 1.4937 | 3.5357 | 0.9496 | 1.3131 | 1.1325 | 1.1435 | 1.1761 | 1.0562 | 1.2008 | 1.0204 |
Hit Data
| Dataset | Hit |
|---|---|
| Protein Concentration | ✘ |
| Protein Localization | ✘ |
| Gene Expression | ✘ |
| Translational Efficiency | ✘ |
Endocytosis
| Temp | Actin Patch (Sac6-tdTomato) | Cortical Patch (Sla1-GFP) | Late Endosome (Snf7-GFP) | Vacuole (Vph1-GFP) |
|---|---|---|---|---|
| 37℃ | ||||
| RT |
Cell Cycle Omics
CYCLoPs (Ecm38-GFP)
| Gene / Allele | Actin Patch (Sac6-tdTomato) | Cortical Patch (Sla1-GFP) | Late Endosome (Snf7-GFP) | Vacuole (Sac6-tdTomato) |
|---|
| Gene | Images |
|---|
| Gene | Images |
|---|
Images are not yet available
Images are not yet available